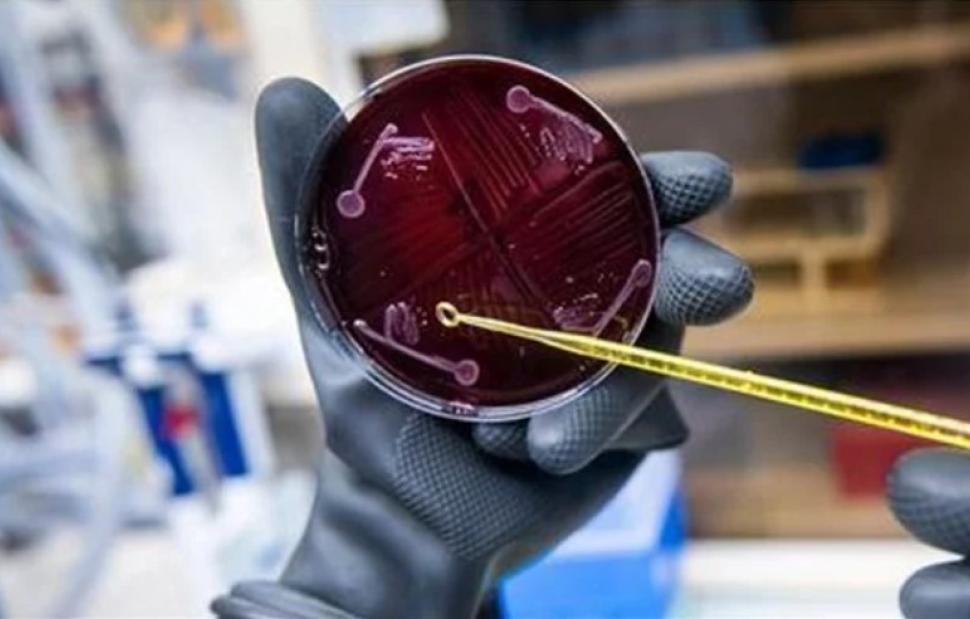

Ανθρώπινο μικροβίωμα ανακοίνωσαν ότι κατάφεραν να δημιουργήσουν σε εργαστήριο επιστήμονες του Πανεπιστημίου Στάνφορντ στις ΗΠΑ.
Είναι η πρώτη φορά που επιτυγχάνεται η τεχνητή δημιουργία μικροβιώματος σε μια εξέλιξη που σύμφωνα με τους ειδικούς μπορεί να ανοίξει τον δρόμο για την ανάπτυξη εξατομικευμένων θεραπειών σε ασθενείς με σοβαρές λοιμώξεις στο γαστρεντερικό σύστημα.
Στον ανθρώπινο οργανισμό κατοικοεδρεύουν αμέτρητοι μικροοργανισμοί στους οποίους οι επιστήμονες έχουν δώσει τον χαρακτηρισμό «μικροβίωμα». Μέχρι από περίπου δύο δεκαετίες δεν γνωρίζαμε την ύπαρξη του μικροβιώματος και γίνεται προσπάθεια καταγραφής και χαρτογράφησης του καθώς και της απόκτησης γνώσεων για τους μηχανισμούς του.
Το πιο γνωστό μικροβίωμα στον ανθρώπινο οργανισμό είναι αυτό που βρίσκεται στο γαστρεντερικό σύστημα και αποτελεί την αποκαλούμενη «χλωρίδα» του. Εκτιμάται ότι το μικροβίωμα των εντέρων του ανθρώπου αποτελείται από περίπου δέκα τρισεκατομμύρια βακτήρια τα οποία βοηθούν στην ομαλή διαδικασία της πέψης ενώ παίζουν ρόλο και στον μηχανισμό του ανοσοποιητικού συστήματος του ανθρώπου.
Οι ερευνητές δημιούργησαν το συνθετικό μικροβίωμα χρησιμοποιώντας 119 είδη βακτηρίων. Ανέμιξαν τα είδη αυτά και στη συνέχεια έκαναν καλλιέργειες για να δημιουργήσουν τη πιο «σταθερή» αποικία την οποία εμφύτευσαν στα πειραματόζωα για να δουν τη λειτουργία της. Όπως διαπιστώθηκε το συνθετικό μικροβίωμα προστάτεψε το γαστρεντερικό σύστημα των ποντικών από επιβλαβή μικρόβια όπως το γνωστό εντεροαιμορραγικό κολοβακτηρίδιο E.coli που ευθύνεται για πολλές λοιμώξεις.
Οι ερευνητές αναφέρουν ότι μετά τη δημιουργία του συνθετικού μικροβιώματος θα αρχίσουν τώρα να εξετάζουν πιο διεξοδικά τη λειτουργία κάθε μικροβίου ξεχωριστά για να αποκαλύψουν τις ιδιότητες και τον ρόλο που παίζουν.
Στόχος είναι να συλλεχθούν τα δεδομένα εκείνα που θα επιτρέψουν στους γιατρούς να δημιουργούν «κοκτέιλ» μικροβίων τα οποία θα δίνουν ως θεραπεία σε ασθενείς με γαστρεντερικά προβλήματα. Κάθε κοκτέιλ θα είναι φτιαγμένο, προκειμένου να ανταποκρίνεται στην πάθηση του κάθε ασθενή.
Ακολουθήστε το Lykavitos.gr στο Google News
και μάθετε πρώτοι όλες τις ειδήσεις